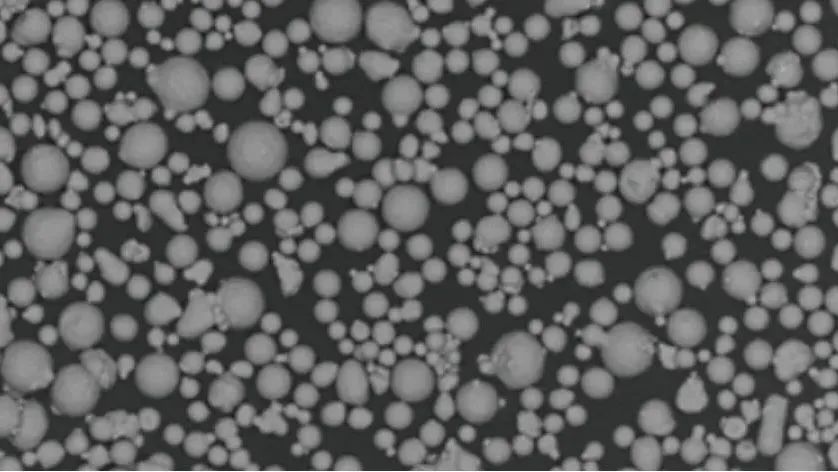
图片

近日,中航迈特迎来发展史上又一重要里程碑——金属粉末总生产炉次突破10万大关!伴随第10万炉次粉末产品的顺利下线,中航迈特已累计生产球形金属粉末产品10,000余吨,并广泛供应全球市场。
10年积淀
从技术突围到行业领跑
2015年11月,中航迈特开启航空航天粉末材料创业征程,十年间,科研团队先后突破多项粉末“卡脖子”关键技术,率先实现了高纯净熔炼雾化制粉技术多工艺路线自主可控,并打通材料循环再生技术,率先具备多种金属材料体系高质量、规模化制备能力,材料服务足迹遍布全球各个国家和地区,实现了从航空航天到生物医疗、汽车模具、消费电子等多个行业领域的拓展,市场占有率始终保持行业前列,逐步成长为具有全球影响力的中国金属3D打印材料品牌,并持续向“科技引领、绿色发展、世界一流的增材制造公司”扎实迈进。

原生工艺+再生技术
创新驱动行业可持续发展
十年淬炼,作为国内金属增材制造材料领域的技术尖兵,中航迈特先后攻克了AVI-VIGA/GA/EIGA/PREP/PA五大国际主流雾化制粉工艺;其中,AVI-EIGA/PA技术先后填补国内空白,AVI-VIGA技术引领粉末制备产业化重大突破,推动行业材料创新、收得率提升及用户使用降本增效。
国产新一代大容量
AVI-VIGA500
引领粉末产业化制备 >>
工业级超高转速AVI-PREP4W
GH4099细粉收得率70%
产能成倍释放 >>
突破工业级AVI-PA30
PA工艺从实验走向量产
TC细粉收得率≥50% >>
中航迈特率先布局金属3D打印粉末循环再生技术,通过多工艺路线融合创新,钛粉再生率达100%,粉末综合性能与原生雾化工艺粉性能一致,每年可为市场新增释放约1800吨优质钛合金细粉(0~53μm),为行业“双碳”目标及可持续发展提供绿色解决方案。

坚持创新驱动,中航迈特持续开展前沿粉末材料研制攻关“揭榜挂帅”,解决高温合金打印微裂纹等成形技术难题,研制成功MT-IN939/X40/GH5188/CM247LC等系列高温合金粉末,开发PREP工艺MT-TC11、MT-Ti65/MT-Ti2AlNb等钛合金粉末,研发国内首款核级制品用304L不锈钢增材粉末,打破国外技术封锁开发自主知识产权AIMgErZr高强铝合金粉末,高性能MT-CoCr01/Ti6Al4V01取得第三类医疗器械注册证等,在前沿材料研究、制备及应用方面始终走在行业前列。
MT-GH5188
MT-X40
MT-IN939
MT-Ti31
MT-Ti65
MT-Ti2AlNb
MT-AlMgErZr
MT-304L
MT-AlMnErZr
200多个牌号+5000吨产能
多元化、规模化成行业标杆
聚焦应用需求,中航迈特构建了多元化金属粉末材料体系,从卓越耐高温性能的MT-GH4099/GH4169/GH3625/GH5188/IN939高温合金,到高比强度的MT-TC4/TC11/TA15/Ti65钛合金,再到高强轻质的MT-AIMgErZr/AlMnErZr铝合金及高性能的MT-18Ni300/304L/316L模具钢、不锈钢,涵盖9大金属类别、200余种粉末产品。

目前,公司已集成/在建原生雾化及再生技术粉末产线40余条,综合年产能达5000吨,满足全球市场对高品质粉末的规模化需求。
10,000吨粉末制备
赋能千行百业增材制造
凭借万吨级高品质金属3D打印粉末的稳定制备,中航迈特金属材料已深度赋能全球增材制造场景,广泛应用于航空航天部件、骨科植入体、口腔牙冠、智能3C终端产品、金属精密模具、运动装备等复杂结构金属制品的高效制造。
MT-IN718
为中欧地平线航空科技项目
提供材料关键技术支持
MT-CoCrMoW
助力纳通增材制造匹配式
人工膝关节假体获批上市
成功研发国内首款核级制品用
MT-304L不锈钢增材粉末
MT-AlMgErZr
入选国家工信部增材制造
典型应用场景名单
MT-TC4等钛合金细粉
为手机、手表等3C行业
提供高强轻质材料支持

MT-316L/AlSi10Mg等
为汽车、模具等行业
提供高性能材料支持

每一炉高品质粉末的制备都是中国新材料产业发展的刻度,站在10年、100,000炉次、10,000吨粉末服务成绩的新坐标上,中航迈特将以技术自主化、材料多元化、产能规模化优势,充分发挥“AI+3D打印材料”、“特种合金+非标3D打印机”融合创新能力,持续突破材料极限,开源赋能,向全球用户提供高端金属3D打印“墨盒材料”,让“中国好材料”闪耀世界舞台。
欢迎转发

千人行业专家交流Q群:248112776
延伸阅读:
1.一种3D打印钛合金新配方:比Ti6Al4V成本更低、性能更好
3.倍丰智能金属3D打印装备挺进头部航空装备集团,顺利通过终期验收
4.3D打印行业常被使用的仿真:从微观组织、无支撑打印到产品功能

228

被折叠的 条评论
为什么被折叠?



